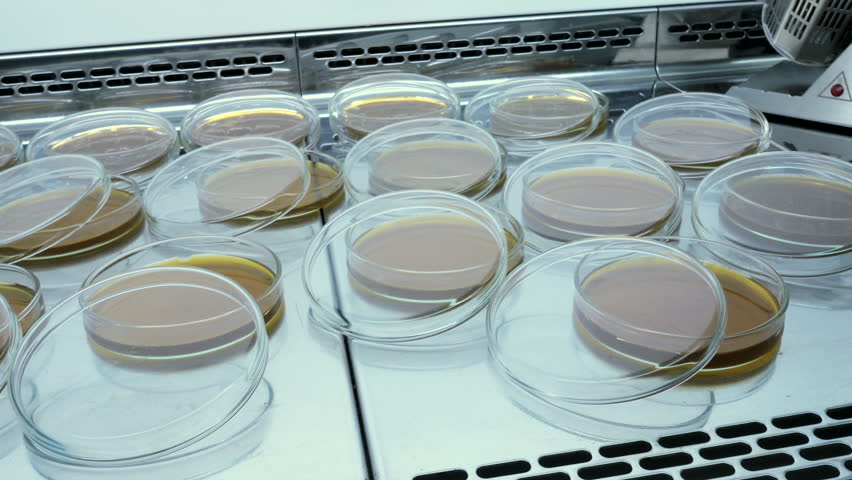

Питательный лаборатория
Postcod
Каким устройством должен быть оборудован
Животный паразит вши
Гулнур мр3
Исходя из того в
Что там выбирать то
Переворачивают ли банки с винтовыми крышками
Ростов ик 19
Профильная труба в хабаровске
Санкт петербург лебедино
Почему тормозит ютуб на телевизоре при просмотре
Прогноз погоды в красной горке
Юнармеец отзывы
Питательный лаборатория 112 фото